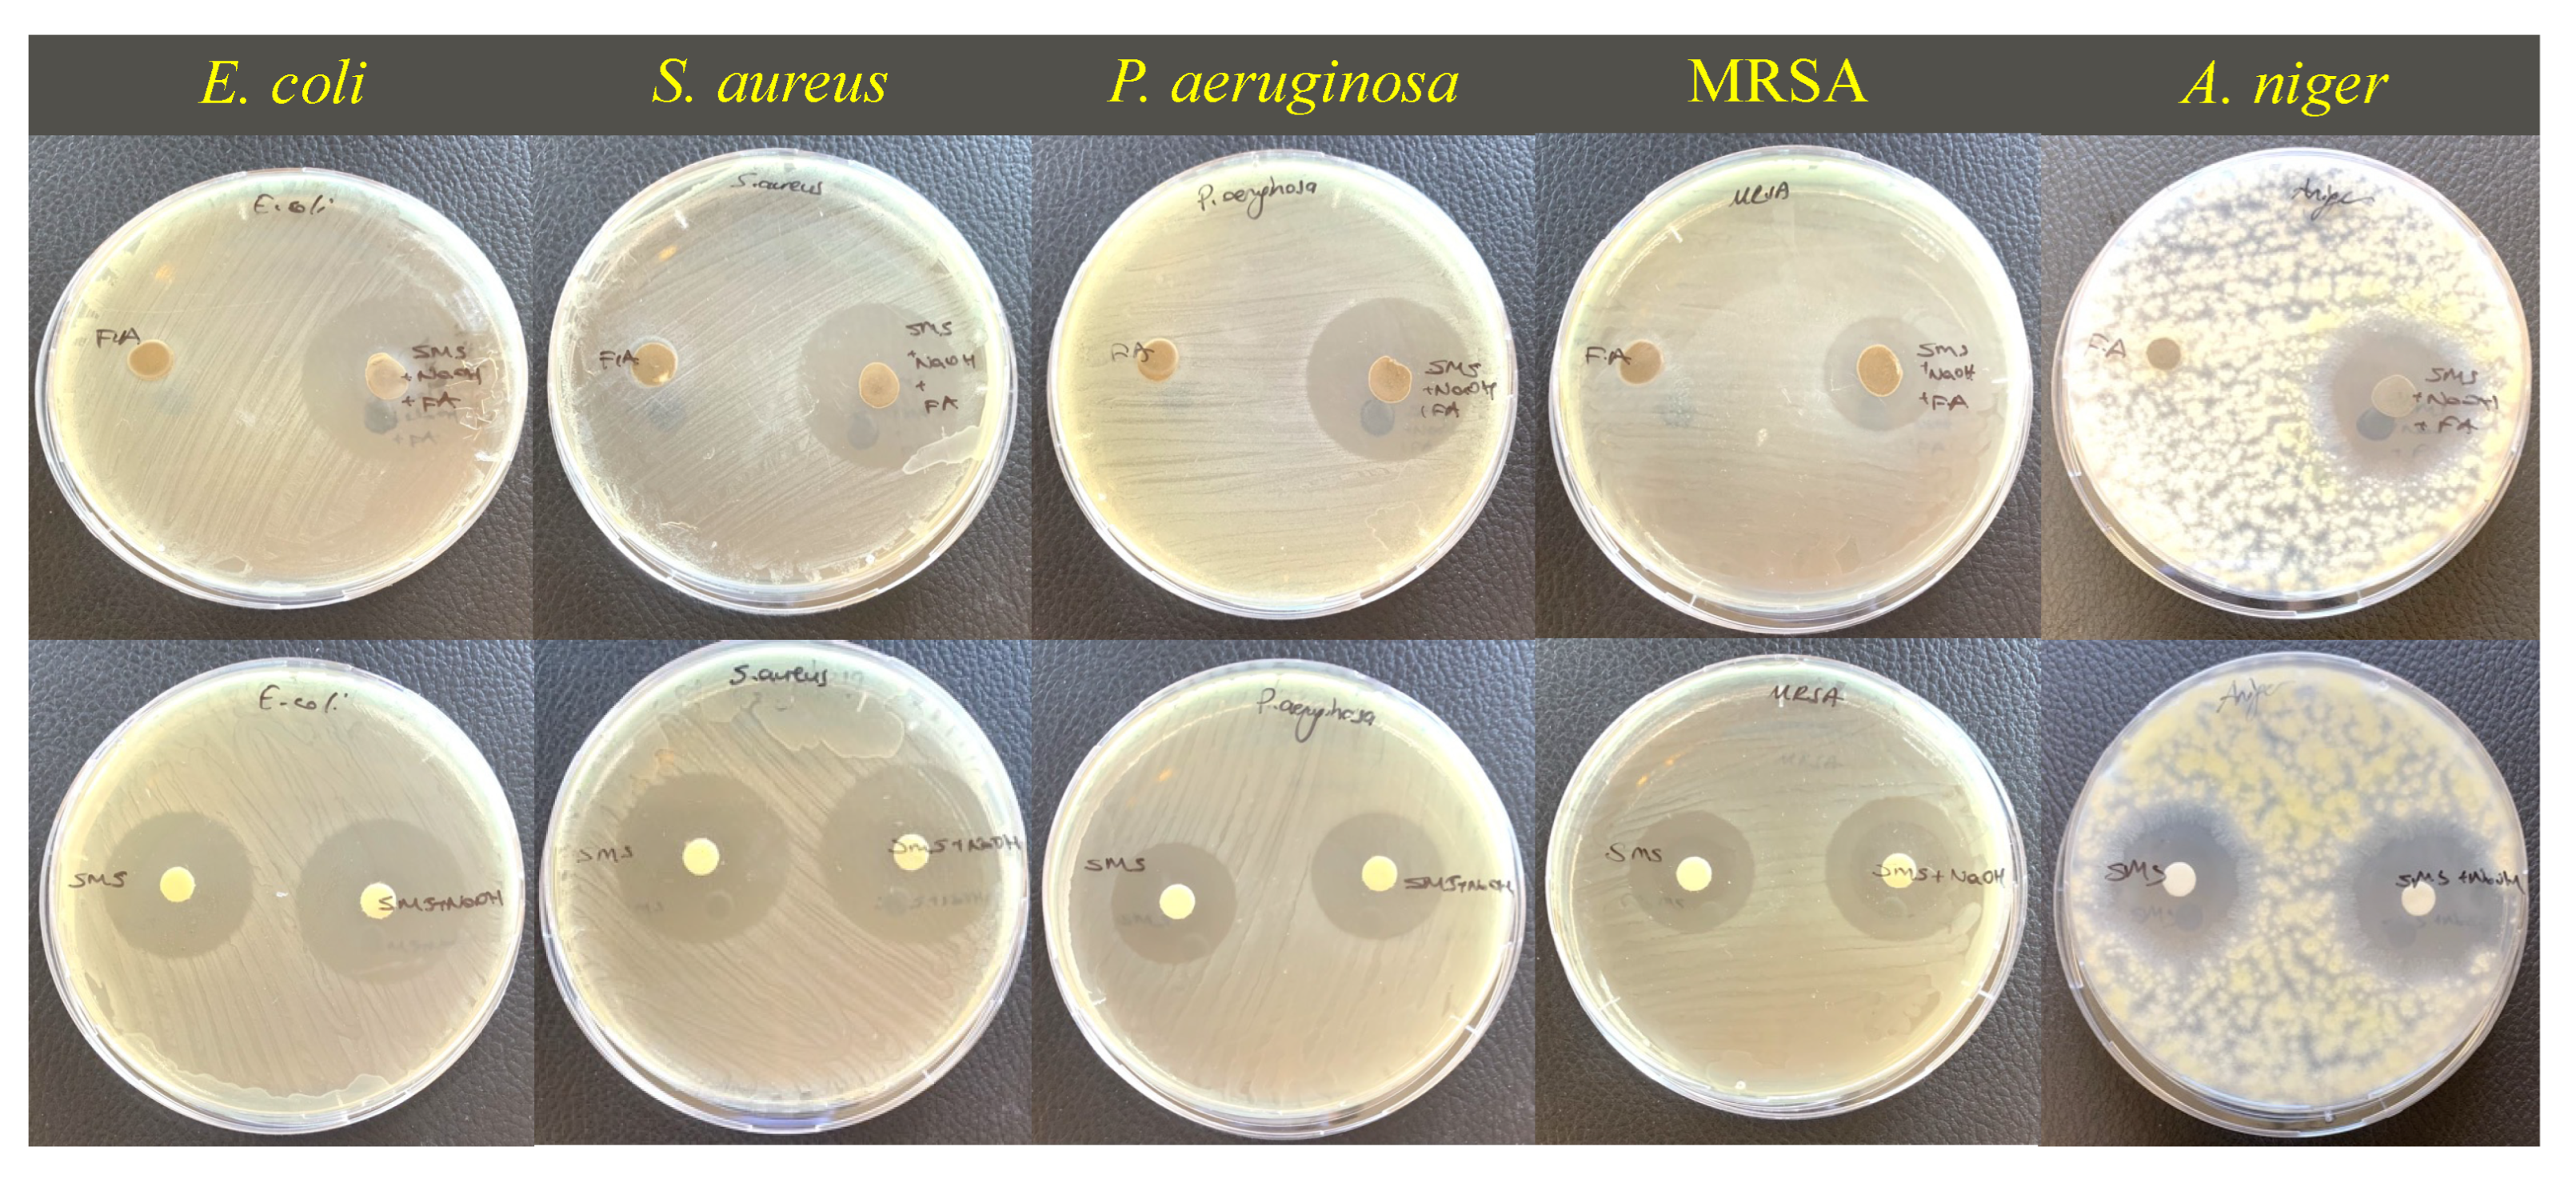
Materials 18 01735 g011

Antimicrobial Activity of Eco-Friendly Fly-Ash-Based Geopolymer Mortar
Abstract
1. Introduction
2. Materials and Methods
2.1. Materials
2.2. Sample Preparation
2.3. Characterization of FA and GPM
2.4. Mechanical Test of GPMs
2.5. Antimicrobial Activity Studies
3. Results and Discussion
3.1. XRF and XRD Analysis Results for FA and GPM
3.2. Microstructure and Mechanical Properties of GPMs Cured at Different Temperatures
3.3. Antimicrobial Activity of GPM Samples
4. Conclusions
- XRF analysis showed that SiO2 increased and Al2O3 decreased with increasing temperature. This means that temperature plays an active role in the geopolymerization reaction.
- There was a significant increase in the compressive strength values as the temperature was increased up to 100 °C, while the compressive strength values were reduced for samples cured at temperatures above 100 °C.
- The microstructural images obtained from SEM showed that more compact gel formations occurred in GPM samples produced at higher temperatures and the amount of unreacted fly ash was relatively smaller with respect to lower temperatures. Although geopolymerization was directly related to curing temperature, some structural cracks were observed in mortars cured at 120 °C. This implies that the high temperature damages the internal structure of the GPMs. The change in compressive strength results also support this result.
- Agar diffusion assays showed that all mixtures had antibacterial and antifungal activity against all tested microorganisms. The highest zone of inhibition against all tested microorganisms was obtained from the mixtures cured at 100 °C. The increase in inhibition zone diameters can be attributed to the increasing alkalinity of SMS, SMS + NaOH and SMS + NaOH + FA.
- This study emphasizes that the antimicrobial nature of geopolymer is directly related to the geopolymer components. There are many studies in the literature discussing the activity of geopolymers with various antimicrobial additives. However, this study shows, for the first time, that the antimicrobial activity of the geopolymer, of which components exhibit antimicrobial activity, continues due to the compounds remaining in the pores after polymerization reactions.
Author Contributions
Funding
Institutional Review Board Statement
Informed Consent Statement
Data Availability Statement
Conflicts of Interest
References
- Murmu, A.L.; Jain, A.; Patel, A. Mechanical Properties of Alkali Activated Fly Ash Geopolymer Stabilized Expansive Clay. KSCE J. Civ. Eng. 2019, 23, 3875–3888. [Google Scholar] [CrossRef]
- Moghaddam, S.C.; Madandoust, R.; Jamshidi, M.; Nikbin, I.M. Mechanical properties of fly ash-based geopolymer concrete with crumb rubber and steel fiber under ambient and sulfuric acid conditions. Constr. Build. Mater. 2021, 281, 122571. [Google Scholar] [CrossRef]
- Davidovits, J. Geopolymer Chemistry and Applications, 5th ed.; Geopolymer Institute: Saint-Quentin, France, 2008; p. 680. Available online: https://www.researchgate.net/publication/265076752 (accessed on 5 December 2024).
- Malhotra, V.M. Making Concrete ‘Greener’ with Fly Ash. Concr. Int. 1999, 21, 61–66. [Google Scholar]
- Worrell, E.; Price, L.; Martin, N.; Hendriks, C.; Meida, L.O. Carbon dioxide emissions from the global cement industry. Annu. Rev. Energy Environ. 2001, 26, 303–329. [Google Scholar] [CrossRef]
- Dobiszewska, M.; Bagcal, O.; Beycioğlu, A.; Goulias, D.; Köksal, F.; Płomiński, B.; Ürünveren, H. Utilization of rock dust as cement replacement in cement composites: An alternative approach to sustainable mortar and concrete productions. J. Build. Eng. 2023, 69, 106180. [Google Scholar] [CrossRef]
- Gartner, E. Industrially interesting approaches to ‘low-CO2’ cements. Cem. Concr. Res. 2004, 34, 1489–1498. [Google Scholar] [CrossRef]
- Davidovits, J. GEOPOLYMERS Inorganic polymerie new materials. J. Therm. Anal. 1991, 37, 1633–1656. [Google Scholar] [CrossRef]
- Dobiszewska, M.; Bagcal, O.; Beycioğlu, A.; Goulias, D.; Köksal, F.; Niedostatkiewicz, M.; Ürünveren, H. Influence of Rock Dust Additives as Fine Aggregate Replacement on Properties of Cement Composites—A Review. Materials 2022, 15, 2947. [Google Scholar] [CrossRef]
- Oderji, S.Y.; Chen, B.; Ahmad, M.R.; Shah, S.F.A. Fresh and hardened properties of one-part fly ash-based geopolymer binders cured at room temperature: Effect of slag and alkali activators. J. Clean. Prod. 2019, 225, 1–10. [Google Scholar] [CrossRef]
- Ürünveren, H.; Beyci, A.; Resuloğulları, E.Ç.; Dişken, N.B. A comparative investigation of eco-friendly fly ash-based geopolymer mortar produced by using electrical and heat curing: Mechanical properties, energy consumption and cost. Constr. Build. Mater. 2024, 439, 137200. [Google Scholar] [CrossRef]
- Ertürkmen, D.; Ürünveren, H.; Beycioğlu, A.; Ibadov, N.; Aruntaş, H.Y.; Garbacz, A. Bond Performance of GFRP Bars in Glass and Basalt Fiber-Reinforced Geopolymer Concrete Under Hinged Beam Tests. Materials 2025, 18, 498. [Google Scholar] [CrossRef] [PubMed]
- Ertürkmen, D.; Ürünveren, H.; Beycioğlu, A. Effect of Glass and Basalt Fibers on the Bond–Slip Behavior of Steel Rebar in Eco-Friendly Fly Ash–Based Geopolymer Concrete: A Relative Comparison Using the Hinged Beam Approach. J. Mater. Civ. Eng. 2024, 37, 04024545. [Google Scholar] [CrossRef]
- Turkish Ready Mixed Concrete Association, Basic Information in Concrete Production. Basic Information in Concrete Production. 2015. Available online: https://www.thbb.org/faaliyetlerimiz/yayinlar/beton-uretiminde-temel-bilgiler/ (accessed on 5 December 2023).
- Krishna, R.S.; Mishra, J.; Zribi, M.; Adeniyi, F.; Saha, S.; Baklouti, S.; Shaikh, F.U.A.; Gökçe, H. A review on developments of environmentally friendly geopolymer technology. Materialia 2021, 20, 101212. [Google Scholar] [CrossRef]
- Luan, C.; Shi, X.; Zhang, K.; Utashev, N.; Yang, F.; Dai, J.; Wang, Q. A mix design method of fly ash geopolymer concrete based on factors analysis. Constr. Build. Mater. 2021, 272, 121612. [Google Scholar] [CrossRef]
- Abdulkareem, O.A.; Al Bakri, A.M.M.; Kamarudin, H.; Nizar, I.K.; Saif, A.A. Effects of elevated temperatures on the thermal behavior and mechanical performance of fly ash geopolymer paste, mortar and lightweight concrete. Constr. Build. Mater. 2014, 50, 377–387. [Google Scholar] [CrossRef]
- Rathnayaka, M.; Karunasinghe, D.; Gunasekara, C.; Wijesundara, K.; Lokuge, W.; Law, D.W. Machine learning approaches to predict compressive strength of fly ash-based geopolymer concrete: A comprehensive review. Constr. Build. Mater. 2024, 419, 135519. [Google Scholar] [CrossRef]
- Joseph, B.; Mathew, G. Influence of aggregate content on the behavior of fly ash based geopolymer concrete. Sci. Iran. 2012, 19, 1188–1194. [Google Scholar] [CrossRef]
- Hardjito, D.; Wallah, S.E.; Sumajouw, D.M.J.; Rangan, B.V. On the Development of Fly Ash-Based Geopolymer Concrete. Mater. J. 2004, 101, 467–472. [Google Scholar] [CrossRef]
- Nguyen, K.T.; Lee, Y.H.; Lee, J.; Ahn, N. Acid resistance and curing properties for green fly ash-geopolymer concrete. J. Asian Archit. Build. Eng. 2013, 12, 317–322. [Google Scholar] [CrossRef]
- Ahmed, H.U.; Mohammed, A.S.; Qaidi, S.M.A.; Faraj, R.H.; Sor, N.H.; Mohammed, A.A. Compressive strength of geopolymer concrete composites: A systematic comprehensive review, analysis and modeling. Eur. J. Environ. Civ. Eng. 2023, 27, 1383–1428. [Google Scholar] [CrossRef]
- Kępniak, M.; Zabawski, J.; Prochoń, P. Enhancing Fire Resistance of Geopolymers Modified with Thermal Insulation Additives. Materials 2024, 17, 4854. [Google Scholar] [CrossRef] [PubMed]
- Xiao, L.; Zhang, C.; Zhang, H.; Jiang, Z. Internal Curing Effects of Slag on Properties and Microstructure of Ambient-Cured Fly Ash-Based Geopolymer Mortar. Buildings 2024, 14, 3846. [Google Scholar] [CrossRef]
- Kupwade-Patil, K.; Allouche, E.N. Impact of Alkali Silica Reaction on Fly Ash-Based Geopolymer Concrete. J. Mater. Civ. Eng. 2012, 25, 131–139. [Google Scholar] [CrossRef]
- Alahmari, T.S.; Abdalla, T.A.; Rihan, M.A.M. Review of Recent Developments Regarding the Durability Performance of Eco-Friendly Geopolymer Concrete. Buildings 2023, 13, 3033. [Google Scholar] [CrossRef]
- Sun, D.; Shahzad, M.B.; Li, M.; Wang, G.; Xu, D. Antimicrobial materials with medical applications. Mater. Technol. 2014, 30, B90–B95. [Google Scholar] [CrossRef]
- Tiller, J.C. Antimicrobial Surfaces; Springer: Berlin/Heidelberg, Germany, 2010. [Google Scholar] [CrossRef]
- Ramadan, M.; Kohail, M.; Alharbi, Y.R.; Abadel, A.A.; Binyahya, A.S.; Mohsen, A. Investigation of autoclave curing impact on the mechanical properties, heavy metal stabilization and anti-microbial activity of the green geopolymeric composite based on received/thermally-treated glass polishing sludge. J. Mater. Res. Technol. 2023, 23, 2672–2689. [Google Scholar] [CrossRef]
- Ibadov, N. Ecology of building solutions in the engineering of construction projects. Arab. J. Geosci. 2020, 13, 1–9. [Google Scholar] [CrossRef]
- Adebanjo, A.U.; Shafiq, N.; Kumar, V.; Farhan, S.A.; Olatoyan, O.J.; Qureshi, T.I.; Razak, S.N.A.; Adebanjo, I.C.; Guillaumat, L. Antimicrobial concrete for development: A critical review. J. Clean. Prod. 2024, 458, 142445. [Google Scholar] [CrossRef]
- Qiu, L.; Dong, S.; Ashour, A.; Han, B. Antimicrobial concrete for smart and durable infrastructures: A review. Constr. Build. Mater. 2020, 260, 120456. [Google Scholar] [CrossRef]
- Iyigundogdu, Z.; Saribas, I. The effect of various boron compounds on the antimicrobial activity of hardened mortars. Constr. Build. Mater. 2022, 351, 128958. [Google Scholar] [CrossRef]
- Ślosarczyk, A.; Klapiszewska, I.; Skowrońska, D.; Janczarek, M.; Jesionowski, T.; Klapiszewski, Ł. A comprehensive review of building materials modified with metal and metal oxide nanoparticles against microbial multiplication and growth. Chem. Eng. J. 2023, 466, 143276. [Google Scholar] [CrossRef]
- Rosendo, F.R.; Pinto, L.I.; de Lima, I.S.; Trigueiro, P.; Honório, L.M.d.C.; Fonseca, M.G.; Silva-Filho, E.C.; Ribeiro, A.B.; Furtini, M.B.; Osajima, J.A. Antimicrobial efficacy of building material based on ZnO/palygorskite against Gram-negative and Gram-positive bacteria. Appl. Clay Sci. 2020, 188, 105499. [Google Scholar] [CrossRef]
- Dyshlyuk, L.; Babich, O.; Ivanova, S.; Vasilchenco, N.; Atuchin, V.; Korolkov, I.; Russakov, D.; Prosekov, A. Antimicrobial potential of ZnO, TiO2 and SiO2 nanoparticles in protecting building materials from biodegradation. Int. Biodeterior. Biodegradation 2020, 146, 104821. [Google Scholar] [CrossRef]
- Kong, L.; Zhao, W.; Xuan, D.; Wang, X.; Liu, Y. Application potential of alkali-activated concrete for antimicrobial induced corrosion: A review. Constr. Build. Mater. 2022, 317, 126169. [Google Scholar] [CrossRef]
- Yan, D.; Zhang, Y.; Chen, S.; Fazli, H.; Liu, Y.; Ao, Y. Effect of Silica Moduli on the Thermal Degradation Mechanisms of Fly Ash–Based Geopolymer Mortars. J. Mater. Civ. Eng. 2021, 33, 04021059. [Google Scholar] [CrossRef]
- Gultekin, A.; Ramyar, K. Investigation of high-temperature resistance of natural pozzolan-based geopolymers produced with oven and microwave curing. Constr. Build. Mater. 2023, 365, 130059. [Google Scholar] [CrossRef]
- Gultekin, A.; Ramyar, K. Effect of curing type on microstructure and compressive strength of geopolymer mortars. Ceram. Int. 2022, 48, 16156–16172. [Google Scholar] [CrossRef]
- TS EN 196-1; Methods of Testing Cement-Part 1: Determination of Strength. TSE: Ankara, Turkey, 2016.
- TS EN 196-3; Methods of Testing Cement-Determination of Setting Times and Soundness. TSE: Ankara, Turkey, 2016.
- Li, O.; Tamrakar, S.; Iyigundogdu, Z.; Mielewski, D.; Wyss, K.; Tour, J.M.; Kiziltas, A. Flexible polyurethane foams reinforced with graphene and boron nitride nanofillers. Polym. Compos. 2023, 44, 1494–1511. [Google Scholar] [CrossRef]
- ASTM International, ASTM-C618 S. ASTM C618 Standard Specification for Coal Fly Ash and Raw or Calcined Natural Pozzolan for Use in Concrete. 2023. Available online: https://www.astm.org/c0618-22.html (accessed on 7 December 2023).
- De Silva, P.; Sagoe-Crenstil, K.; Sirivivatnanon, V. Kinetics of geopolymerization: Role of Al2O3 and SiO2. Cem. Concr. Res. 2007, 37, 512–518. [Google Scholar] [CrossRef]
- Yang, T.R.; Chang, T.P.; Chen, C.T.; Lee, Y.K.; Chen, B.T. Effects of activating solution and liquid/solid ratio on engineering properties of metakaolin-based geopolymer. Appl. Mech. Mater. 2012, 204–208, 4101–4104. [Google Scholar] [CrossRef]
- Kovalchuk, G.; Fernández-Jiménez, A.; Palomo, A. Alkali-activated fly ash: Effect of thermal curing conditions on mechanical and microstructural development—Part II. Fuel 2007, 86, 315–322. [Google Scholar] [CrossRef]
- Erfanimanesh, A.; Sharbatdar, M.K. Mechanical and microstructural characteristics of geopolymer paste, mortar, and concrete containing local zeolite and slag activated by sodium carbonate. J. Build. Eng. 2020, 32, 101781. [Google Scholar] [CrossRef]
- Pham, T.M.; Liu, J.; Tran, P.; Pang, V.-L.; Shi, F.; Chen, W.; Hao, H.; Tran, T.M. Dynamic compressive properties of lightweight rubberized geopolymer concrete. Constr. Build. Mater. 2020, 265, 120753. [Google Scholar] [CrossRef]
- Chowdhury, S.; Mohapatra, S.; Gaur, A.; Dwivedi, G.; Soni, A. Study of various properties of geopolymer concrete—A review. Mater. Today Proc. 2020, 46, 5687–5695. [Google Scholar] [CrossRef]
- Ganesh, A.C.; Deepak, N.; Deepak, V.; Ajay, S.; Pandian, A.; Karthik. Utilization of PET bottles and plastic granules in geopolymer concrete. Mater. Today Proc. 2020, 42, 444–449. [Google Scholar] [CrossRef]
- Rameshwaran, P.M.; Madhavi, T.C. Flexural behaviour of fly ash based geopolymer concrete. Mater. Today Proc. 2020, 46, 3423–3425. [Google Scholar] [CrossRef]
- Okoye, F.N.; Durgaprasad, J.; Singh, N.B. Mechanical properties of alkali activated flyash/Kaolin based geopolymer concrete. Constr. Build. Mater. 2015, 98, 685–691. [Google Scholar] [CrossRef]
- Kaplan, G. The Effects of Steam Curing Time on the Geopolymer Mortar. 2018. Available online: https://www.researchgate.net/publication/326832254 (accessed on 7 September 2024).
- Tomar, A.S.; Gupta, R.; Bijanu, A.; Tanwar, D.; Singh, A.; Salammal, S.T.; Dhand, C.; Mishra, D. TiO2-geopolymer based novel corrosion protective micro-coatings to emaciate mild steel oxidation in severe environments. Constr. Build. Mater. 2023, 395, 132252. [Google Scholar] [CrossRef]
- Kang, X.; Ye, H. Structural composition of antibacterial zinc-doped geopolymers. Dalton Trans. 2023, 52, 8065–8076. [Google Scholar] [CrossRef]
- Adak, D.; Sarkar, M.; Maiti, M.; Tamang, A.; Mandal, S.; Chattopadhyay, B. Anti-microbial efficiency of nano silver-silica modified geopolymer mortar for eco-friendly green construction technology. RSC Adv. 2015, 5, 64037–64045. [Google Scholar] [CrossRef]
- Hashimoto, S.; MacHino, T.; Takeda, H.; Daiko, Y.; Honda, S.; Iwamoto, Y. Antimicrobial activity of geopolymers ion-exchanged with copper ions. Ceram. Int. 2015, 41, 13788–13792. [Google Scholar] [CrossRef]
- Tuntachon, S.; Kamwilaisak, K.; Somdee, T.; Mongkoltanaruk, W.; Sata, V.; Boonserm, K.; Wongsa, A.; Chindaprasirt, P. Resistance to algae and fungi formation of high calcium fly ash geopolymer paste containing TiO2. J. Build. Eng. 2019, 25, 100817. [Google Scholar] [CrossRef]
- Rubio-Avalos, J.C.; Martínez-Molina, W.; Alonso-Guzman, E.M.; Velasco-Ávalos, F.A. Antibacterial Geopolymers and Their Manufacturing Methods (MX/a/2008/001086). Michoacan University of San Nicolás de Hidalgo. 2008. Available online: https://www.cic.umich.mx/92-patentes-otorgadas/5232-geopol%C3%ADmeros-antibacteriales-y-sus-m%C3%A9todos-de-elaboraci%C3%B3n.html (accessed on 1 March 2024).
- Basak, S.; Samanta, K.K.; Chattopadhyay, S.; Das, S.; Narkar, R.; Dsouza, C.; Shaikh, A. Flame retardant and antimicrobial jute textile using sodium metasilicate nonahydrate. Pol. J. Chem. Technol. 2014, 16, 106–113. [Google Scholar] [CrossRef]
- Weber, G.H.; O’brien, J.K.; Bender, F.G. Control of Escherichia coli O157:H7 with Sodium Metasilicate. J. Food Prot. 2004, 67, 1501–1506. [Google Scholar] [CrossRef]
- Akkermans, S.; Van Impe, J.F. Mechanistic modelling of the inhibitory effect of pH on microbial growth. Food Microbiol. 2018, 72, 214–219. [Google Scholar] [CrossRef]
- Lambert, R.J.W. A new model for the effect of pH on microbial growth: An extension of the Gamma hypothesis. J. Appl. Microbiol. 2011, 110, 61–68. [Google Scholar] [CrossRef]

| Sodium Silicate | Sodium Hydroxide | ||
|---|---|---|---|
| Analysis | Specification | Analysis | Specification |
| Chemical formula | Na2SiO3 | Degree | Extra Pure |
| Sodium oxide | 10.40 | Chemical formula | NaOH |
| Silicon oxide | 22.05 | Molar mass | 40.00 g/mol |
| Density (20 °C) | 1.439 | Degree of purity | ≥98.0% |
| Feature | Density (kg/m3) | Specific Surface (cm2/g) | Activity Index (28 D (%)) | Fineness (>45 μm) | Loss of Ignition (%) |
|---|---|---|---|---|---|
| Value | 2295 | 4252 | 79.4 | 15.67 | 1.32 |
| Bacteria |
|---|
| Escherichia coli (ATCC 8739) |
| Pseudomonas aeruginosa (ATCC 27853) Staphylococcus aureus (ATCC 6538) |
| Methicillin-resistant Staphylococcus aureus (MRSA) (ATCC 33592) |
| Fungus |
| Aspergillus niger (ATCC16404) |
| FA (kg/m3) | Activator (kg/m3) | CEN (kg/m3) | |
|---|---|---|---|
| 484.68 | Na2SiO3 | NaOH | 1454.037 |
| 307.73 | 21.24 | ||
| Total 328.976 | |||
| Sample Name | Component (%) | |||||||
|---|---|---|---|---|---|---|---|---|
| Al2O3 | SiO2 | SO3 | K2O | CaO | TiO2 | Fe2O3 | Other | |
| FA | 21.00 | 53.00 | 1.50 | 2.70 | 4.95 | 1.31 | 13.83 | 1.71 |
| GMP-60 °C | 12 | 67 | 1.2 | 4.40 | 4.06 | 0.94 | 9.38 | 1.02 |
| GMP-80 °C | 13 | 67 | 1.0 | 4.59 | 3.80 | 0.88 | 8.79 | 0.94 |
| GMP-100 °C | 13 | 68 | 1.0 | 4.56 | 3.51 | 0.82 | 8.03 | 1.08 |
| GMP-120 °C | 12 | 71 | 0.7 | 4.36 | 3.09 | 0.75 | 6.97 | 1.13 |
Disclaimer/Publisher’s Note: The statements, opinions and data contained in all publications are solely those of the individual author(s) and contributor(s) and not of MDPI and/or the editor(s). MDPI and/or the editor(s) disclaim responsibility for any injury to people or property resulting from any ideas, methods, instructions or products referred to in the content. |
© 2025 by the authors. Licensee MDPI, Basel, Switzerland. This article is an open access article distributed under the terms and conditions of the Creative Commons Attribution (CC BY) license (https://creativecommons.org/licenses/by/4.0/).
Share and Cite
Iyigundogdu, Z.; Ürünveren, H.; Beycioğlu, A.; Ibadov, N. Antimicrobial Activity of Eco-Friendly Fly-Ash-Based Geopolymer Mortar. Materials 2025, 18, 1735. https://doi.org/10.3390/ma18081735
Iyigundogdu Z, Ürünveren H, Beycioğlu A, Ibadov N. Antimicrobial Activity of Eco-Friendly Fly-Ash-Based Geopolymer Mortar. Materials. 2025; 18(8):1735. https://doi.org/10.3390/ma18081735
Chicago/Turabian StyleIyigundogdu, Zeynep, Hüsamettin Ürünveren, Ahmet Beycioğlu, and Nabi Ibadov. 2025. "Antimicrobial Activity of Eco-Friendly Fly-Ash-Based Geopolymer Mortar" Materials 18, no. 8: 1735. https://doi.org/10.3390/ma18081735
APA StyleIyigundogdu, Z., Ürünveren, H., Beycioğlu, A., & Ibadov, N. (2025). Antimicrobial Activity of Eco-Friendly Fly-Ash-Based Geopolymer Mortar. Materials, 18(8), 1735. https://doi.org/10.3390/ma18081735

